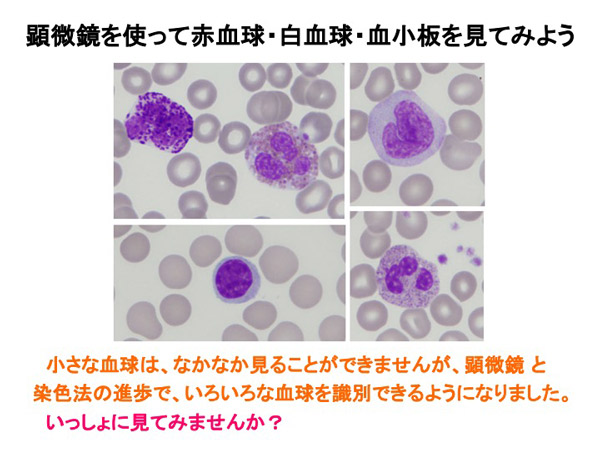

ワークショップの紹介
顕微鏡を使って
赤血球・白血球・血小板を見てみよう
小さな血球は、なかなか見ることができませんが、顕微鏡と染色法の進歩で、いろいろな血球を識別できるようになりました。
いっしょに、見てみませんか。
実習風景
![]() |
![]() |
![]() |
![]() |
参加者の声(実施後アンケートから)
- 赤血球は大体わかっていたけど白血球はあまり知らなかったので知れて良かった
- 家ではできない実験が出来て楽しかった
- 血球を全種類しっかり見たのは初めてだったので面白かった
- 素直に楽しかった
- 色々なものが見れてよかったし形も分かった
- 思ったよりもきれいに見えてすごいと思った
- つかれた
- 楽しかった